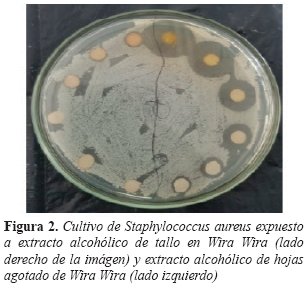

Resumen: Introducción: El uso de plantas con diversos fines etnomedicinales es una práctica ancestral y actualmente común en una vasta parte de la población de Bolivia. Objetivo general: Identificar si la wira wira y cerraja de nuestro medio poseen actividad antimicrobiana contra bacterias patógenas y determinar su toxicidad a través del bioensayo de pruebas biológicas. Materiales y Métodos: Estudio descriptivo; Universo, Wira Wira recolectada del Valle Alto de Cochabamba y Cerraja de Cercado; Muestra, se obtuvo de forma aleatoria un kilogramo de Wira Wira y Cerraja respectivamente; Métodos, se emplearon diferentes técnicas para la extracción de los principios activos, se realizaron pruebas biológicas para determinar la toxicidad de los mismos y se determinó la actividad antimicrobiana por el método de difusión en agar. Resultados: Wira wira demostró actividad antimicrobiana con 4 extractos; alcohólico de tallo, flor y alcohólico agotado de hojas frente a E. faecalis y S. aureus, y acuoso de hojas frente a P. aeruginosa y S. aureus. Por otro lado no se evidencio actividad antibacteriana de los extractos de cerraja. Conclusiones: Wira wira es candidata para estudios posteriores destinados a la identificación del o los compuestos activos puros con actividad antibacteriana, hecho respaldado por los resultados obtenidos en esta y otras investigaciones. Los extractos de cerraja, a diferencia de los resultados obtenidos de otros trabajos, no presentaron actividad antimicrobiana, demostrando la posibilidad y vinculación de la variación en los compuestos de la planta con el ecosistema en el que se desarrolla.
Palabras clave:Técnicas In VitroTécnicas In Vitro,Agentes AntibacterianosAgentes Antibacterianos,AchyroclineAchyrocline,SonchusSonchus.
Abstract: Introduction: The use of plants with various ethnomedicinal purposes is an ancestral practice and currently common in a vast part of the population of Bolivia. General objective: To identify if the extracts of both plants present in our environment have antimicrobial activity against pathogenic bacteria and to determine their toxicity through the bioassay of biological tests. Materials and Methods: Descriptive study; Universe, Wira Wira collected from Valle Alto in Cochabamba and Cerraja collected from Cercado; Sample, we obtained one kilogram of each, Wira Wira and Cerraja randomly; Methods, different techniques were used to extract the active ingredients, biological tests were performed to determine their toxicity and antimicrobial activity was determined by the agar diffusion method. Results: Wira Wira demonstrated antimicrobial activity with 4 extracts; stem alcoholic, flower and alcoholic depleted of leaves against E. faecalis and S. aureus, and aqueous of leaves against P. aeruginosa and S. aureus. On the other hand, there was no evidence of antibacterial activity with the cerraja extracts. Conclusions: Wira Wira is a candidate for further studies aimed at the identification of the pure active compound (s) with antibacterial activity, all this backed up by the positive results in the agar diffusion tests grown with pathogenic bacteria. Unlike the results that demonstrate the antibacterial activity of the Cerraja in research carried out in other parts of the world, it is not the case of the one in our territory, whose extracts did not present any antimicrobial activity, demonstrating the possibility and linking the variation in plant compounds with the ecosystems in which it develops.
Keywords: In Vitro Techniques, Anti-Bacterial Agents, Achyrocline, Sonchus.
Artículos Originales
ACTIVIDAD ANTIMICROBIANA DE WIRA WIRA Y CERRAJA CONTRA ESTAFILOCOCO, ENTEROCOCO, PSEUDOMONAS Y ESCHERICHIA
ANTIMICROBIAL ACTIVITY OF WIRA WIRA AND CERRAJA AGAINST STAPHYLOCOCCUS, ENTEROCOCCUS, PSEUDOMONAS AND ESCHERICHIA
Universidad Mayor de San Simón

Esta obra está bajo una Licencia Creative Commons Atribución-NoComercial-CompartirIgual 4.0 Internacional.
Recepción: 22 Abril 2019
Aprobación: 11 Abril 2020
Bolivia es un país que cuenta con una magna riqueza natural, destacando la amplia variedad en la flora. Diversas especies de plantas son utilizadas en la práctica de la medicina tradicional y empírica por sus efectos simbólicos o reales para el ser humano, sobre todo en las poblaciones rurales1. Achyrocline satureioides (wira wira) especie perteneciente a la familia de las asteráceas, es una planta medicinal utilizada ampliamente en muchas regiones de los Andes de Bolivia por sus propiedades antiinflamatorias, antiespasmódica, antitusígena, así como el empleo sobre heridas superficiales para evitar infecciones2-5. Su conocida actividad antimicrobiana se relaciona a la presencia de metabolitos secundarios, como ser: flavonoides, esteroles, triterpenos, saponinas, ácidos cafeoilquínicos y aceites esenciales, que otorgan esta cualidad a la planta6,7. Sonchus oleraceus (cerraja) es una planta nativa de Europa, Mediterráneo y el occidente de Asia. Ha sido introducida en el resto del mundo y se reporta estudios en los cuales se encuentra actividad antimicrobiana atribuida a los compuestos fenólicos (flavonoides y cumarinas) que contiene esta planta. También son conocidas las propiedades etnomedicinales, las infusiones son empleadas para tratar los síntomas del resfrío, dolores de garganta, diarrea, y heridas infectadas8-12.El presente trabajo se realiza con el fin de determinar el poder antibacteriano que poseen estas dos plantas en nuestra región (Cercado y Valle Alto de Cochabamba), en vista de que puede existir variaciones en los compuestos activos de las plantas de acuerdo a la zona geográfica en la cual se desarrollan, pudiendo así ocasionar diferencias en la actividad que tienen contra las bacterias patógenas.
Se realizó un estudio de tipo descriptivo donde las muestras seleccionadas fueron 2 géneros de plantas medicinales pertenecientes a la misma familia; Achyrocline satureioides (wira wira) obtenida del Valle Alto de Cochabamba y Sonchus oleraceus (cerraja) obtenida de Cercado - Cochabamba y 4 tipos de bacterias; Staphylococcus aureus 25923, Enterococcus faecalis 29212, Pseudomonas aeuroginosa 2785 3, y Escherichia coli 25922 (cepas ATCC).
Las variables independientes fueron las plantas de estudio de las cuales se obtuvieron extractos acuosos por hidrodestilación, extractos alcohólicos y alcohólico agotado de raíz, hoja, tallo y flor de Achyrocline satureioides y Sonchus oleraceus. (Figura 1)

Figura 1.
Extractos alcohólicos de sonchus aleroceus
Para realizar el Bioensayo se obtuvieron quistes de artemias, los cuales fueron incubados en las condiciones necesarias para conseguir su eclosión y desarrollo. Posteriormente se expusieron grupos de 10 artemias adultas a diferentes concentraciones de los extractos (10, 20, 50, 70 y 100 mg/ml) en viales con 5ml de solución salina durante 24 horas.
Las variables dependientes, sensibilidad y resistencia, se determinaron a través del método de difusión en agar, para lo cual se fabricaron sensidiscos de 6mm de diámetro por 0.5 de ancho, impregnados a diferentes concentraciones de los extractos (3,125; 6,25; 12.5; 25; 50; 100 mg/ml). Los mismos fueron aplicados en la superficie de un cultivo inoculado con bacterias. El antimicrobiano difundió desde el disco al medio de cultivo produciendo una zona de inhibición las cuales fueron medidas respecto al diámetro ocasionado.
La investigación tuvo lugar en el centro de tecnología agroindustrial del laboratorio de pruebas biológicas de la Universidad Mayor de San Simón, realizándose en sus instalaciones el Bioensayo con artemias y el método de difusión en agar. Con los datos recolectados se realizó el estudio que consistió en organizar, relacionar y analizar la información utilizando los programas Excel y Word. No se manipularon resultados en el presente trabajo.
A través del bioensayo de pruebas biológicas se determinó la toxicidad y mortalidad que causaron los diferentes extractos de estas plantas frente a la artemia salina. Se encontraron altos niveles de mortalidad en los grupos de artemias expuestas a los componentes de Wira Wira, entre un 65% a 95% perecieron al entrar en contacto durante 24 horas con las diferentes concentraciones de los extractos (Tabla 1). De la cerraja se obtuvieron resultados que no sobrepasaron el 20% de mortalidad frente a los extractos alcohólicos a concentraciones de 100 mg/ml. Sin embargo, las artemias expuestas a los extractos acuosos presentaron una mortalidad de 65 a 90% a concentraciones de 10mg/ml. (Tabla 2). En los ensayos de susceptibilidad antimicrobiana por difusión en agar frente a S. aureus y E. faecalis se observó que el extracto alcohólico de tallo fue el que presentó mayor efectividad con un halo de inhibición de 9 mm de diámetro a la concentración mínima inhibitoria de 3.125 mg/ml. En el caso del extracto alcohólico de flor este demostró un halo de 9 - 11 mm frente a estas bacterias a concentraciones de 6.25 mg/ml. Ambos extractos causaron halos inhibitorios con un rango de 18 a 24 mm de diámetro a concentraciones de 50 y 100 mg/ml respectivamente. El extracto acuoso de hojas fue el único que inhibió a P. aeruginosa con un halo de 8 mm de diámetro a una concentración de 100 mg/ml. (Tabla 3). No se demostró ningún halo de inhibición en los cultivos expuestos a los extractos de la Cerraja.

Tabla 1.
Bioensayo con artemias – toxicidad de los extractos de wira wira.

Tabla 2.
Bioensayo con artemias – toxicidad de los extractos de cerraja.
*Grupo de artemias testigo no expuestas a los extractos
Nota. Revisar la sección de discusión en la cual se aclara la posible causa de la muerte de las artemias en el grupo testigo.

Tabla 3.
Actividad antimicrobiana de wira wira
La actividad antimicrobiana que se obtiene con los extractos del tallo y flor de wira wira frente a S. aureus y E. faecalis son comparables a los demostrados en otras investigaciones donde se utiliza partes iguales de la planta y las mismas cepas ATCC. 2-4,18,19 (Figura 2). Por otro lado, se encuentra actividad antimicrobiana en el extracto acuoso de hojas de wira wira contra P. aeruginosa, hecho que destaca al ser esta una bacteria fármaco resistente y estar relacionada a muchas patologías20-22. E. coli demuestra resistencia a los extractos de wira wira en esta investigación al igual que en otras.

Figura 2.
Cultivo de Staphylococcus aureus expuestoa extracto alcohólico de tallo en Wira Wira (ladoderecho de la imágen) y extracto alcohólico de hojasagotado de Wira Wira (lado izquierdo)
Nuestros resultados sugieren que existe una actividad antibacteriana más efectiva frente a bacterias grampositivas, lo cual puede obedecer a que las gramnegativas poseen una membrana externa y una espacio periplásmico único. (Duffy and Power, 2001)23.
No se obtuvo resultados que evidencien poder antimicrobiano de los extractos obtenidos de cerraja procedente de Cercado - Cochabamba frente a las cepas problema, hallazgo que difiere de otras investigaciones en las que se demuestra la actividad antimicrobiana8,11,12. Esta diferencia puede deberse a los múltiples factores que afectan la composición de la planta, desde el ecosistema en el que se desarrolla hasta los factores ambientales de cada región24.
Debe considerarse que en esta investigación se trabajó con extractos no purificados de ambas plantas lo cual reduce en gran medida la actividad antibacteriana real de las sustancias puras que poseen las mismas, requiriendo así dosis de mayor concentración para producir halos de inhibición bacteriana.
El bioensayo con artemias se realiza con el fin de detectar la bioactividad de los compuestos heterogéneos de los extractos de wira wira y cerraja sin identificar ni purificar un compuesto activo específico, permitiendo así determinar el efecto letal de los mismos en organismos vivos 13-15. Resulta importante su aplicación en el descubrimiento y desarrollo de nuevas sustancias de origen natural con un potencial favorable a poseer actividad antimicrobiana y un posible paso para el desarrollo de nuevos fármacos. Los extractos de wira wira que presentan mayor actividad antimicrobiana causan una elevada mortalidad en los grupos de artemias. Se observa que las artemias testigo, grupo no expuesto a la intervención, perecen en proporción comparable a las que son expuestas a los extractos, hecho que no se evidencia en los demás grupos. Esto podría ocurrir por una propiedad de alta volatilización de un compuesto de la planta que contaminaría los medios viales de las artemias testigo, o bien por las variantes del desarrollo de las artemias según Vanhaecke y Persoone15,16.
En el caso de la cerraja, los extractos acuosos y extractos alcohólicos agotados de hojas presentan un nivel de toxicidad considerable en los grupos de artemias expuestas respectivamente, incluyendo a los grupos testigo. Se obtienen bajos niveles de mortalidad con los extractos restantes.
Con la presente investigación podemos concluir que en Cochabamba - Bolivia, Achyrocline satureioides posee actividad antibacteriana, resaltando la obtenida de los extractos de flor y tallo. Por otro lado no se evidencia poder antimicrobiano de los extractos que se obtienen de Sonchus oleraceus frente a las cepas problema. Los extractos de Achyrocline satureioides demuestran altos niveles de mortalidad en el bioensayo con artemias, hecho que no se observa con la mayoría de los extractos de Sonchus oleraceus.
http://www.scielo.org.bo/scielo.php?script=sci_arttext&pid=S1817-74332020000100003&lng=es&nrm=iso (html)
Al Centro de Tecnología Agroindustrial del laboratorio de pruebas biológicas de la Universidad Mayor de San Simón por facilitar sus instalaciones para que fuera posible la realización de esta investigación. Al Lic. M. Sc. Ricardo Sahonero Irahola por el conocimiento brindado facilitando recursos para el desarrollo de este trabajo. A la Magister Adriana Santa Cruz por su gran apoyo, asesoría y gran interés en ayudarnos a alcanzar esta meta. A nuestros colegas de investigación en especial a Horacio Villaroel Villazón y Paul Cavero Del Granado por su participar en la recolección de datos para la realización de este proyecto.
Correo: Santiagoanaya98@hotmail.com
Teléfono: +59176984255

Figura 1.
Extractos alcohólicos de sonchus aleroceus

Tabla 1.
Bioensayo con artemias – toxicidad de los extractos de wira wira.

Tabla 2.
Bioensayo con artemias – toxicidad de los extractos de cerraja.
*Grupo de artemias testigo no expuestas a los extractos
Nota. Revisar la sección de discusión en la cual se aclara la posible causa de la muerte de las artemias en el grupo testigo.

Tabla 3.
Actividad antimicrobiana de wira wira
Figura 2.
Cultivo de Staphylococcus aureus expuestoa extracto alcohólico de tallo en Wira Wira (ladoderecho de la imágen) y extracto alcohólico de hojasagotado de Wira Wira (lado izquierdo)
